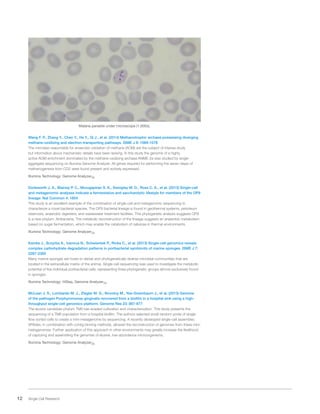
12 Single Cell Research
Malaria parasite under microscope (1,000x).
Wang F. P., Zhang Y., Chen Y., He Y., Qi J., et al. (2014) Methanotrophic archaea possessing diverging
methane-oxidizing and electron-transporting pathways. ISME J 8: 1069-1078
The microbes responsible for anaerobic oxidation of methane (AOM) are the subject of intense study
but information about mechanistic details have been lacking. In this study the genome of a highly
active AOM enrichment dominated by the methane-oxidizing archaea ANME-2a was studied by single-
aggregate sequencing on Illumina Genome Analyzer. All genes required for performing the seven steps of
methanogenesis from CO2 were found present and actively expressed.
Illumina Technology: Genome AnalyzerIIx
Dodsworth J. A., Blainey P. C., Murugapiran S. K., Swingley W. D., Ross C. A., et al. (2013) Single-cell
and metagenomic analyses indicate a fermentative and saccharolytic lifestyle for members of the OP9
lineage. Nat Commun 4: 1854
This study is an excellent example of the combination of single-cell and metagenomic sequencing to
characterize a novel bacterial species. The OP9 bacterial lineage is found in geothermal systems, petroleum
reservoirs, anaerobic digesters, and wastewater treatment facilities. This phylogenetic analysis suggests OP9
is a new phylum: Atribacteria. The metabolic reconstruction of the lineage suggests an anaerobic metabolism
based on sugar fermentation, which may enable the catabolism of cellulose in thermal environments.
Illumina Technology: Genome AnalyzerIIx
Kamke J., Sczyrba A., Ivanova N., Schwientek P., Rinke C., et al. (2013) Single-cell genomics reveals
complex carbohydrate degradation patterns in poribacterial symbionts of marine sponges. ISME J 7:
2287-2300
Many marine sponges are hosts to dense and phylogenetically diverse microbial communities that are
located in the extracellular matrix of the animal. Single-cell sequencing was used to investigate the metabolic
potential of five individual poribacterial cells, representing three phylogenetic groups almost exclusively found
in sponges.
Illumina Technology: HiSeq, Genome AnalyzerIIx
McLean J. S., Lombardo M. J., Ziegler M. G., Novotny M., Yee-Greenbaum J., et al. (2013) Genome
of the pathogen Porphyromonas gingivalis recovered from a biofilm in a hospital sink using a high-
throughput single-cell genomics platform. Genome Res 23: 867-877
The elusive candidate phylum TM6 has evaded cultivation and characterization. This study presents the
sequencing of a TM6 population from a hospital biofilm. The authors selected small random pools of single-
flow-sorted cells to create a mini-metagenome by sequencing. A recently developed single-cell assembler,
SPAdes, in combination with contig binning methods, allowed the reconstruction of genomes from these mini-
metagenomes. Further application of this approach in other environments may greatly increase the likelihood
of capturing and assembling the genomes of elusive, low-abundance microorganisms.
Illumina Technology: Genome AnalyzerIIx

This document provides an overview of recent single cell research publications featuring Illumina technology. It describes applications of single cell sequencing in cancer research, metagenomics, stem cells, immunology and other areas. It discusses techniques for sample preparation, data analysis, and sequencing of DNA, epigenetics and RNA at the single cell level. The document includes a bibliography of reviewed publications demonstrating the use of Illumina sequencing for single cell analysis.